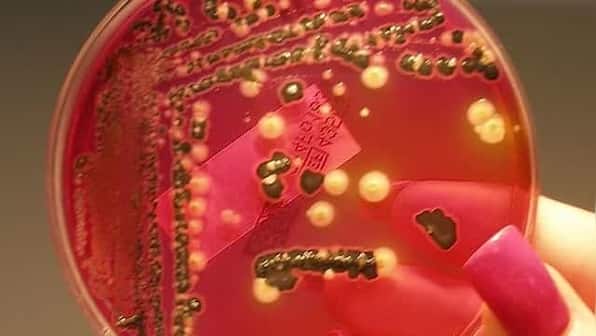

Ever since the COVID-19 pandemic started, researchers and the public around the world have been trying to understand how different viruses jump ship from plants and other animals to humans. Food poisoning does not seem as dangerous as COVID-19 infection right now, but it can be debilitating, and scientists might have found out just how salmonella — a type of bacteria that causes salmonellosis — is jumping from species to species to spread infection. Salmonella is an infiltrator to worry about Researchers based out of the University of Delaware, USA, have discovered that certain wild strains of salmonella are bypassing the immune system of green leafy vegetables like lettuce. The study, published in Frontiers in Microbiology, indicates that some strains of these bacterial pathogens that can affect humans severely are forcing plants’ closed stomates (the pores found on the epidermis of leaves, stems and other organs of plants, which also house guard cells like parenchyma) to open up through brute force. Salmonella is then able to enter the plants, bypass their immune system and then infect humans and other animals when consumed. Because these salmonella strains are inside the plant and not on the surface, simply washing the veggies cannot get rid of them. The study also shows that plants which are farmed to get more yields already have a low immune system, which makes the infiltration by salmonella easy. Ultimately, what this study shows is that salmonellosis is not a type of infection that only passes from animals to humans, but can also be transmitted from plants to other animals and humans – a cross-species jump that’s bound to remind you of contagions like the new coronavirus. How to prevent salmonellosis Clearly then, salmonellosis is a bacterial infection you should worry about and take precautions against every single day. This is not just because it causes a type of food poisoning that leads to stomach cramps and diarrhoea, but also because these symptoms can be very severe too. The Cleveland Clinic says that older people, infants, those with bowel diseases or digestive disorders, and those who are immunosuppressed or immunocompromised (like cancer, HIV or AIDS patients) are at a very high risk of becoming severely sick due to salmonella infection. Prevention is the best thing you can do against this infection which can affect you and your loved ones. Here are some safe practices you must use to prevent salmonella infection: • Don’t just wash the veggies and fruits, but also the cutting boards, knives, countertops and utensils that the cut fruits and veggies have been in contact with. This is important because the salmonella is now proven to be inside the produce as well as on the outside. This step will help you avoid cross-contamination. • Always wash your hands with soap and water before and after handling food to avoid cross-contamination. • Cook veggies, eggs, poultry and all your food at a high temperature (40 degrees Fahrenheit or 4.5 degrees Celsius is recommended). • Keep your refrigerator below 40 degrees Fahrenheit or 4.5 degrees Celsius, and keep your freshly bought veggies, fruits and other foods that can be spoiled in it. • Do not consume fish, eggs, meat, unpasteurised milk or cheese and other high-risk foods raw. Yes, that means putting sushi, rare steaks and half-fried/undercooked eggs off your plate. • If someone in your household has salmonella infection, ensure that their toilets are disinfected regularly because this bacteria is also found in stool samples, and can spread further from unclean bathrooms. Always close the lid of the toilet before flushing. For more information, read our article on Salmonella Infection: Symptoms, causes, treatment and prevention. Health articles in Firstpost are written by myUpchar.com, India’s first and biggest resource for verified medical information. At myUpchar, researchers and journalists work with doctors to bring you information on all things health.
Salmonellosis is a bacterial infection you should worry about and take precautions against every single day.
Advertisement
End of Article

)

)
)
)
)
)
)
)
)



